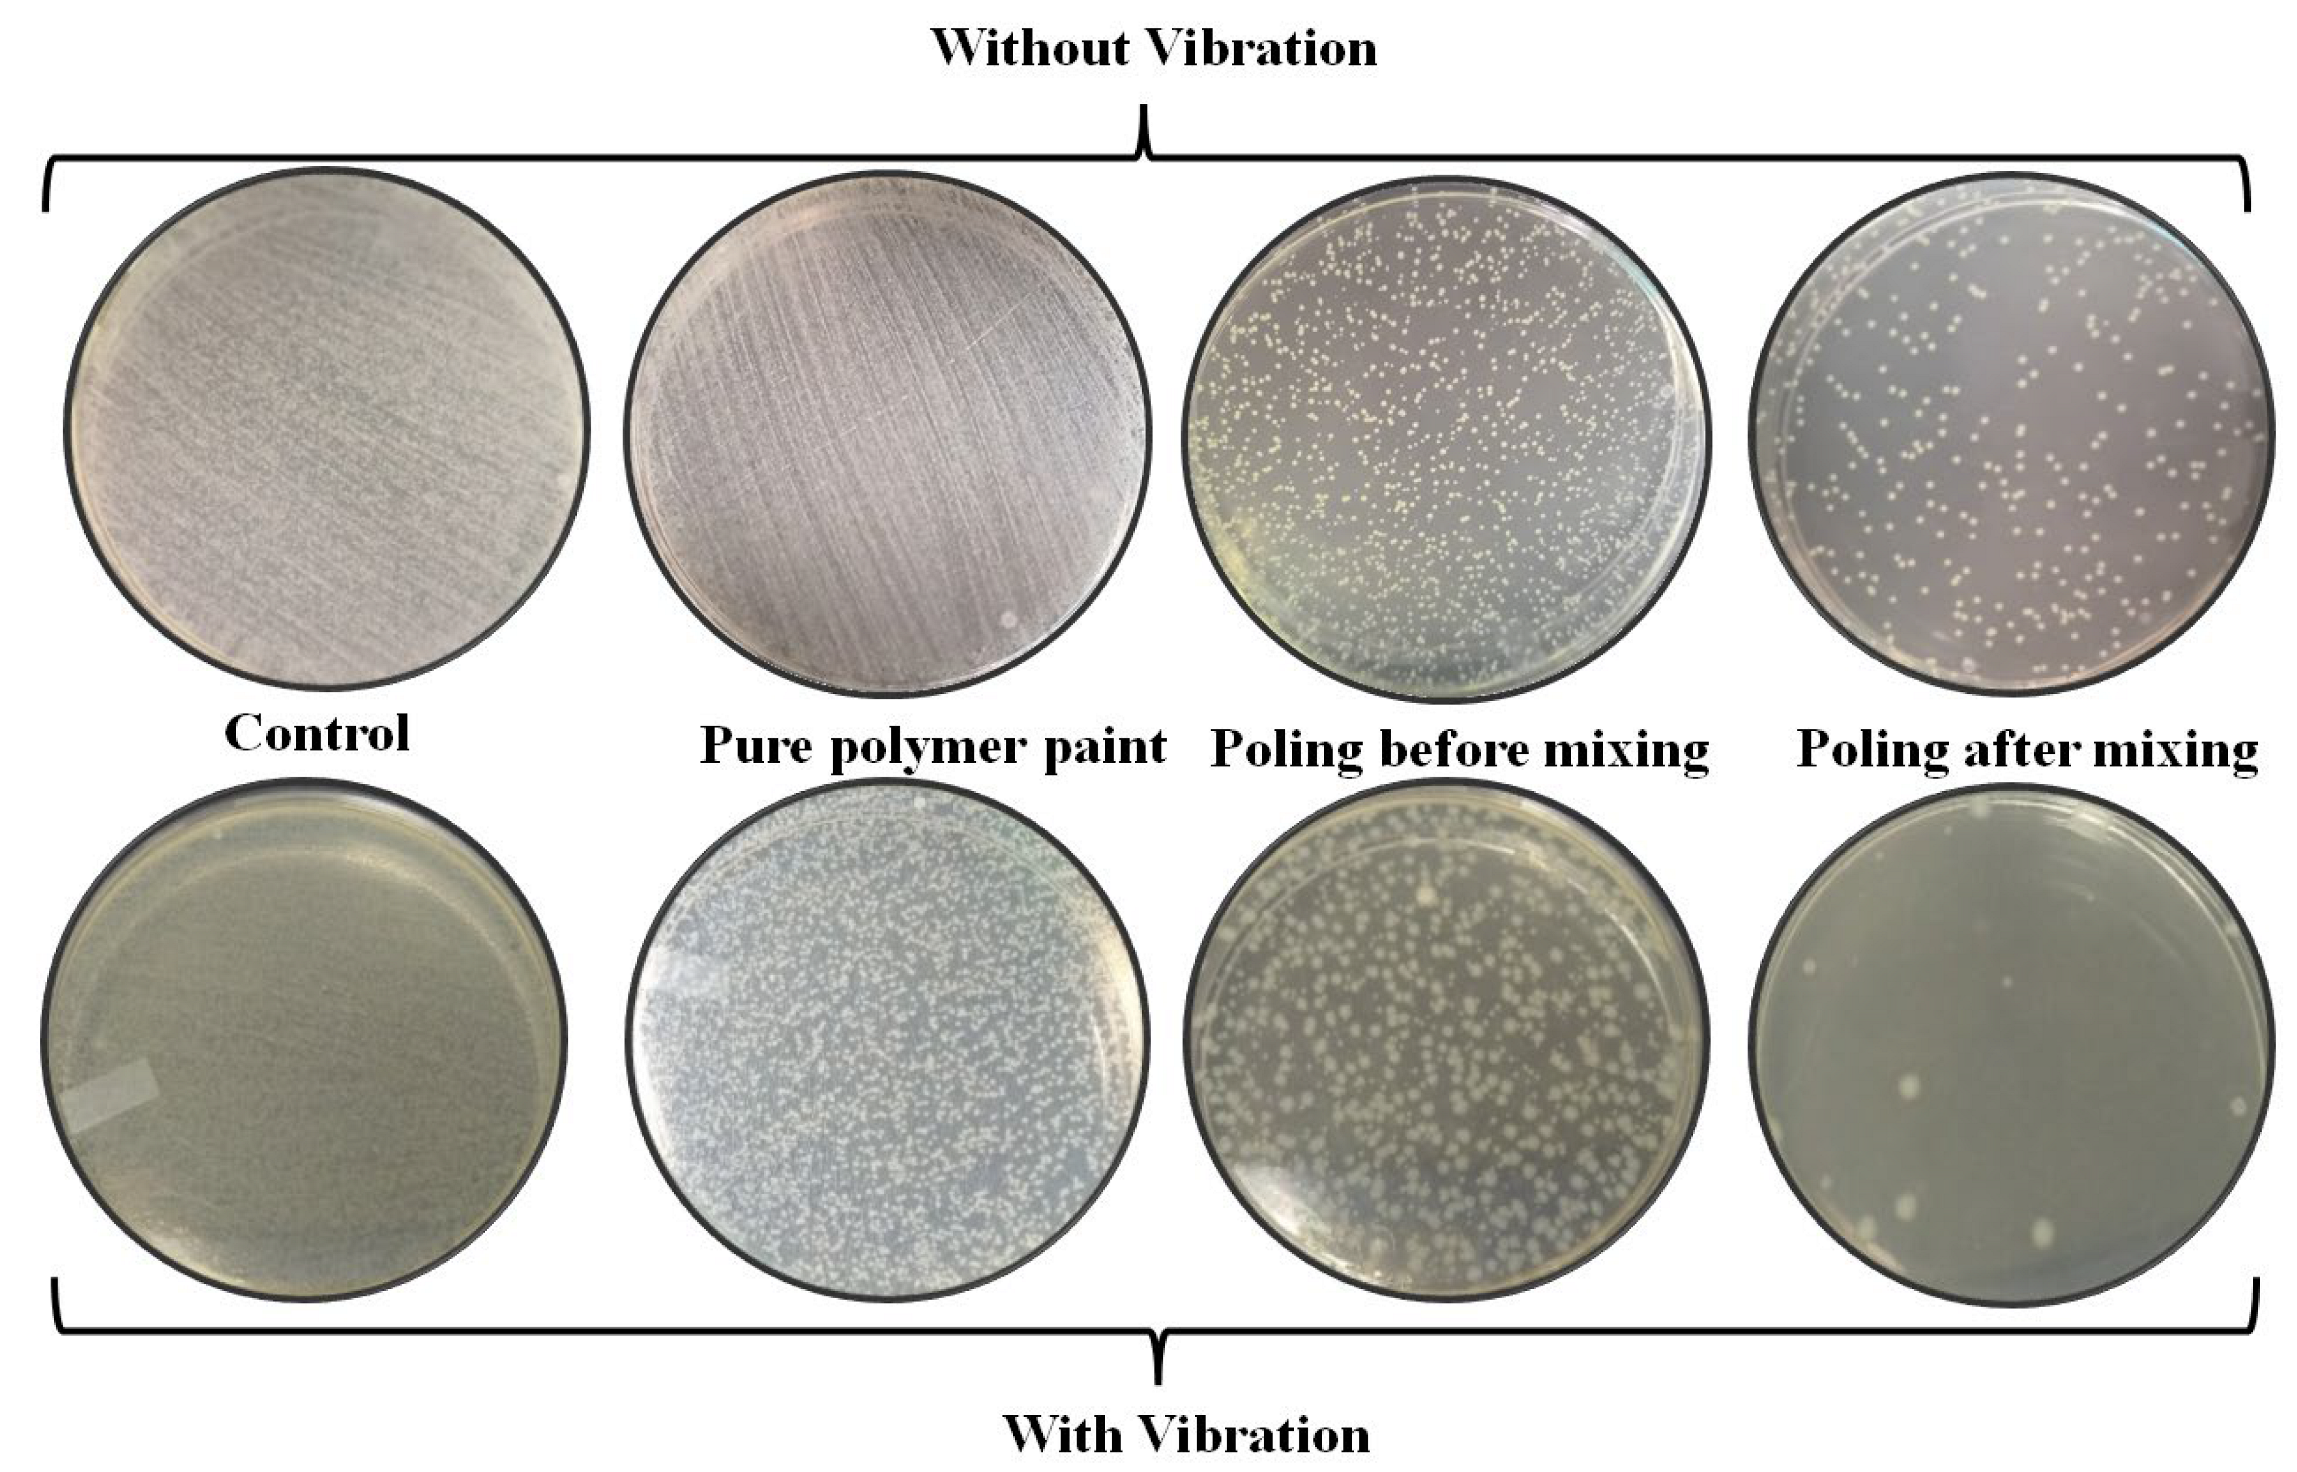
Catalysts 12 01228 g007 Catalysts 12 01228 g007

Abstract
BaTiO3-polymer paint composites were fabricated to examine piezocatalysis activities. Dye degradation and antibacterial activities were recorded under ultrasonication. The effect of polarization was also examined for the catalysis process. There were significant enhancements in catalysis performance in the poled sample; 80–90% dye degradation was recorded (240 min) in poled samples of BaTiO3-polymer paint composites. The above observations indicate that these composites can be utilized as coatings for self-cleaning applications.
1. Introduction
Ferroelectric materials have shown promising photocatalysis, piezocatalysis, piezo-photocatalysis, and pyrocatalysis effects [1,2,3]. This is because of the fact that this family of materials has remnant polarization, which participates in increasing efficiency (in the case of photocatalysis), electro-mechanical (piezocatalysis), and thermoelectric coupling (in the case of pyrocatalysis) [4,5]. Due to the piezoelectric nature and semiconductor behavior, ferroelectric materials have demonstrated piezocatalysis effects. Researchers have reported a wide range of ferroelectric and piezoelectric materials for piezocatalysis. These materials are BaTiO3, ZnO, LiNbO3, K0.5Na0.5NbO3, Bi4Ti3O12, BiFeO3, etc. [6,7,8,9,10,11,12,13,14,15]. These reports mainly comprise piezocatalysis under ultrasonic vibration for the dye degradation process. It is noted that ultrasonic vibration includes mechanical vibration (on the catalytic surface) and creates several other phenomena such as cavitation and abnormal local temperature increases [16,17,18,19,20,21]. These side effects can also involve the dye degradation process, also known as sonocatalysis [22]. Sonocatalysis is widely known, even in the case of non-ferroelectric materials. Hence, sonocatalysis is not reported in piezoelectric-based piezocatalysis in non-centrosymmetric materials [23,24,25]. There is a still debate in the literature about distinguishing piezocatalysis effects from sonocatalysis [16].
The piezocatalysis effect can be easily filtered out using the following strategies: (1) The effect of poling: only piezocatalysis can respond to the poling effect and (2) low frequency: a lower frequency than ultrasonic vibration can prevent sonocatalysis [16]. Another critical challenge is to explore the utilization of piezocatalysis for certain applications. Recently, novel applications to remove scale from teeth have been reported. In this study, piezoelectric particles were mixed in toothpaste [26]. There are also a few studies where biomedical treatment has been done by using piezocatalysis [8]. For most of the applications, materials should be flexible and compatible with manufacturing. For this solution, polymer composites are the most popular. These composites can be used in different shapes. There is some literatures on polymer composites for piezocatalysis applications [11,27,28,29,30]. Surface coating is a kind of polymer composite. Coating of piezoelectric composites can be an essential strategy towards piezocatalytic application. This study is planned to explore polymer/BaTiO3 composites for piezocatalysis dye degradation. The effect of electric poling is also investigated to confirm piezocatalysis signals from the composites.
2. Results and Discussion
BaTiO3 was selected to produce composites for piezocatalysis dye and bacterial degradation. In the past, BaTiO3 was extensively explored for piezocatalysis applications. Due to its stability, moderate catalysis effect, and simple chemical composition, it attracts more chance of commercialization than any other materials of the ferroelectric family. Here, its composites were made with a polymer paint used for coating applications. It was selected as it is commercially available and has other suitable properties required for coating applications. Fifty percent of each ingredient was mixed thoroughly and manually coated on a steel substrate to achieve maximum effect. After drying, it was characterized for microstructure, phase, and catalytic behavior. Figure 1 shows the XRD plots for polymer paint, BT ceramic powder, and its composites.

Figure 1.
XRD patterns of BaTiO3 ceramics powder, BaTiO3-polymer composite sample and polymer paint.
Well-defined crystalline structures could be observed in all the three XRD scans. The BT phase was presented, as it was well-matched with the with JCPDS (00-075-0462) file from tetragonal. At the same time, the composite XRD indicated the presence of polymer and BT phases in it. Hence, it can be interpreted that the composite has BT phases, and there is no other undesired reaction of BT with the polymer during composite fabrications. It was difficult to identify phases present in the polymer paint. This is due to the fact that commercial polymer paint was selected in this study. A study using commercial polymer paint is more appropriate and viable for technology aspects. To study the effect of poling conditions, these composites were fabricated in three states, i.e., unpoled BT was mixed with polymer (strategy 1), BT powder was first poled using the corona poling technique and subsequently mixed with polymer (strategy 2), and unpoled BT was mixed with polymer and subsequently poled using corona poling (strategy 3). All these three cases are graphically shown in Figure 2. From the literature, it is clear that poling has an impactful influence on piezocatalytic/photocatalytic behavior [5,31]. Electrical poling is the process of re-orientation of ferroelectric domains unidirectionally. Typically, this is an essential step for demonstrating the piezoelectric effect in polycrystalline ferroelectric ceramics. It is well reported using the electrode-based application of electric field on parallel plate capacitor geometry. However, it can only be done in the case of bulk samples.

Figure 2.
Typical fabrication steps for BaTiO3 composite samples.
Corona poling is another technique for poling the powered sample, as electrodes cannot be deposited on the powdered samples. Generally, it is assumed that each particle of ferroelectric ceramics may have multiple random electrical domains in a pristine state. This results in zero net polarization in each particle, i.e., no piezoelectricity can be expected from these individual particles. On the other hand, after poling, each particle will demonstrate effective polarization with unidirectional domains, and hence each particle can be individually piezoelectric. Note that the corona poled-powered sample is free to change its orientation. Finally, the cumulative polarization of all the particles present in the powered sample batch will be zero. Hence, poling of the powered sample has no meaning in view of bulk piezoelectric applications (d33 = 0). However, in the catalytic viewpoint, it is not compulsory to have global (bulk) piezoelectricity, as catalytic reactions trigger from each molecule locally after interacting with individual piezoelectric active poled ceramic particles. In other words, local piezoelectricity may be sufficient for piezocatalytic activities. Some of the literature supports this statement [32,33]. With this hypothesis and understanding the impact of electric poling described above, three strategies were considered in the present study. In the case of strategy 3, where BT/polymer composites were poled, piezoelectric behavior can be exhibited in bulk, as there is an effective remnant polarization into it, unlike strategy 2, where composites have only local piezoelectricity despite the absence of macroscopic piezoelectric response. From a technological viewpoint, strategy 2 is most suitable, handy, and quick compared to strategy 3. A subsequent study explained their further characterization. The SEM images along with the EDX of BT, polymer, and composite surfaces are presented in Figure 3. BT particles were found to be spherical and uniform in the range of around 1–2 microns. There were no specific features observed in the polymer surface as expected. Composite micro images clearly showed a uniform, crack-free formation on composites (Figure 3a–d). Further elemental area mappings indicated the homogeneous distribution of BT, as Ba and Ti colors were uniformly distributed within the selected area, as shown in Figure 3e,f.

Figure 3.
(a,b) SEM images of BT, (c) polymer paint, and (d) BT-polymer composite. (e) Element mapping of polymer paint, and (f) BT-polymer composite.
To understand its piezocatalytic performance, these composite coatings were submerged in RB dye aqueous solution, and ultrasonic vibrations were exposed. To avoid any effect (other than piezocatalysis), many experiments were performed. Only the RB dye solution, only the polymer coating, and composites samples according to strategy 2 and strategy 3 were analyzed. The catalytic effect was measured using UV-vis spectroscopy using a predefined calibration curve. Figure 4a,b images are the typical signatures of dye degradation behavior in absorption plots at different time scales. Both the images clearly showed better activity in poled BT/polymer composites where poling was done after fabrication of composites (strategy 3 in Figure 2). Similar wavelength scans were also recorded for other standard samples (only dye, only polymer, and unpoled composites), not shown here. Figure 4c shows the estimated degradation for all the considered samples in the same conditions. Unambiguous interpretation can be made, as only poled samples (strategies 2 and 3 of Figure 2) outperformed compared to that of unpoled, only dye, and polymer samples. Here, it is essential to discuss the effect of ultrasonic vibration on dye degradation. Ultrasonic vibrations cause several abnormal well-reported phenomena such as cavitation and its further impacts. This cavitation participates in catalysis using very high local temperature and pressure. It has also been reported that the rupture of bubbles may also radiate electromagnetic spectra, which may induce photocatalytic activity. At this moment, it is not easy to dig into this matter further. However, it can be assumed that these ultrasonic waves can equally influence all the samples (poled/unpoled). Hence, the difference in performance between poled and unpoled can be attributed to intrinsic piezoelectric behavior.

Figure 4.
(a,b) Absorbance spectra of RB dye during piezocatalytic performance of the BT-polymer composite paint before and after mixing, (c) C/C0 vs. time plots, and (d) kinetic rate constant for all the samples.
Poled (BT-polymer paint) samples (strategy 3) showed the best performance among the studied samples. The second-best samples were prior-poled BT-mixed polymer composites (strategy 2). Because of the other advantages associated with strategy 2, it is recommended that overall, strategy 2 is more favorable. Another point to be noted is that the catalytic splitting of organic molecules requires reactive oxygen species. For this, electron/holes need to be transferred on the surface of catalytic materials. In the case of composites, all the BT particles are expected to be covered with the polymer used in the matrix. On the application of vibration, electrons and holes can be assumed on the surfaces of the BT. As BT is assumed to be completely covered with polymer and still demonstrating the catalytic effect, it can be inferred that the polymer matrix can transfer sufficient charge species on the surfaces for further chemical reactions. It is challenging to dig more into the role of polymer in catalysis, as this is the first study in this direction. The first-order kinetic rate was calculated by using Equation (1).
The role of the matrix in piezocatalysis or photocatalysis is equally important, as it permits charge transfer during catalysis. Figure 4d is the plot of rate constants for various experiments. These rate constants were needed to compare catalytic performance with other materials. Due to the piezoelectric nature and semiconductor behavior, ferroelectric materials demonstrated the piezocatalysis effect. The piezocatalysis reactions are shown in Equations (2)–(6).
Figure 5a shows the repeated performance of the studied composites. Almost the same performance warranted its potential uses. At the same time, it should also be noted that the mechanical robustness of composites is also essential, as coating materials should be physically strong. In this article, these are not investigated as this line of research is beyond the scope of this article. Fortunately, all the experiments were done with ultrasonic vibrations, which are assumed to have a powerful impact on composites. The repeated and persistent performance also indicated the stability of composites, as no degraded performance was recorded. To identify responsible reactive oxygen species (ROS) during piezocatalysis with the help of a scavenger test, during the scavenger test, three different types of scavengers were used, namely, p-benzoquinone (superoxide (O2−)), ethylenediaminetetraacetic acid (holes (h+)), and isopropyl alcohol (hydroxyl (OH). Figure 5b shows the maximum decrease in the presence of isopropyl alcohol. It indicates that hydroxyl (OH) radicals are responsible for the catalysis reaction.

Figure 5.
(a) Re-usability and (b) scavenger test during piezocatalytic activities.
The CFU/mL experiment was conducted, as it is the gold standard for assessing the antibacterial activity of materials. The antibacterial activity of the BT-polymer paint along with the control is shown in Figure 6. Both the poled samples (poled before mixing with polymer paint and poled after mixing with polymer paint) exhibited antibacterial activity without vibration, as shown in Figure 6a. However, the BT-polymer paint samples poled after mixing showed better results, where only 30% of the bacteria survived after exposure for 180 min, as compared to 60% bacterial survival with sample poled before mixing. The remnant surface charge over the surface of BT particles due to poling is attributed to the micro electrolysis of water molecules. This micro electrolysis results in reactive oxygen species (ROS) in the aqueous system [34,35,36,37]. The ROS may affect the bacterial cells adversely at multiple targets, including cell membrane and internal cell organelles such as mitochondria, ribosomes, and genetic material [38,39,40]. It is noted that this bacteria-killing performance is due to surface charges on the BaTiO3 sample. These surface charges cannot kill bacteria for prolong periods of time, as the charge leaks out after the first contact. It is essential to have vibration input energy to generate continuous charges on the surfaces to have an active surface. The introduction of vibration through ultrasonication fastens the bacterial degradation rate, and almost complete eradication of bacterial cells was observed in 180 min, as shown in Figure 6b. Significant death was observed in the control and pure polymer paint samples, which may be attributed to the cavitation effect of ultrasonication in the aqueous system [40]. Figure 7 depicts the digital pictures of colony-forming units plated on solidified agar media. Overall, the effect of the electrical poling was clearly visible and evident in the above-mentioned experimental observations.

Figure 6.
(a,b) Survival percentage of E. coli bacteria cell colonies under different conditions.

Figure 7.
Real-time images of E. coli bacteria cell colonies after 180 min.
3. Experimental
Ferroelectric BaTiO3(BT) was prepared using a solid-state reaction route. High purity reagents (AR grade, Merck chemicals, Mumbai, India) of BaCO3 (99% pure) and TiO2 (99% pure) powders were taken as the raw materials. The mixture was calcined at 1050 °C for four hours to obtain the single-phase BaTiO3. The phase formation characterization of the calcined sample was done using the powder X-ray diffraction (XRD) technique employing Cu-Kα radiation (Smartlab, Rigaku, Tokyo, Japan). Polymer (Asian, white paint (50 wt.%)) and BaTiO3 (50 wt.%) composite samples were prepared. Composite paste was painted (using a brush) on a rectangular frame. A structural study of cement-based composites was performed through X-ray diffraction (Rigaku Smart Lab, Tokyo, Japan) and a scanning rate of 2°/min for 2θ ranging between 20° and 70°. The microstructure was obtained using scanning electron microscopy (FEI SEM NOVA Nanosem 450, Hillsboro, OR, USA). Then the composite sample and powder sample were poled with the help of corona poling (3 kV/mm).
To determine piezocatalytic degradation activities in prepared specimens, rhodamine B (RB dye) was selected as a representative pollutant in the water. In a typical procedure, the catalyst was subjected to sonication in a quartz crucible containing 10 mL of the aqueous dye solution. During the piezocatalytic experiments, an RB dye solution of ~5 mg/L initial concentration was taken in the quartz crucible, and composite samples were merged into it. Further, the quartz crucible was stored in the dark for 24 h to balance adsorption–desorption equilibrium between the prepared ceramic acting as a catalyst and the dye. Continuous sonication (Ultrasonic 40 kHz and 70 W) was provided during the piezocatalytic experiment, and the test samples were collected every 30 min. These samples were scanned using a UV-visible spectrophotometer to quantify the degradation.
The samples were tested for antibacterial activity under vibration and without vibration to assess the antibacterial effect of BT-polymer composites. The method adopted for this study was colony forming units/mL (CFU/mL) of Escherichia coli (E. coli) under different predetermined conditions. E. coli was selected for antibacterial study, since E. coli is one of the most abundant bacteria present in natural sources ranging from the human body to water and air. The detailed process of the CFU/mL experiment is described elsewhere [34,41,42]. A 100 μL aliquot of bacterial suspension was withdrawn from the stock solution and mixed with 9.9 mL of LB broth. The mixture was incubated at 37 °C for 12 h under agitation (180 rpm). A working culture of 1 × 106 cells/mL was obtained from the parent suspension. A sample size of 1 × 1 inch was submerged in separate vessels containing the bacterial suspension and were marked for identification. One set of containers containing samples and bacterial suspension was exposed to ultrasonic vibrations, and another group was kept at mild agitation (50 rpm) to prevent bacterial cell sedimentation. At predetermined times, an aliquot of 100 μL was taken from each vessel and distributed over solidified agar material in a petri plate following repeated dilutions. The petri plates were incubated in a BOD incubator for 12 h at 37 °C. To calculate the CFU/mL for each vessel, the colony-forming units in each petri plate were counted, and the results were multiplied by the dilution factor. Results are reported in percent survival and standard deviation in relation to control, with each reading being done three times.
4. Conclusions
BaTiO3-polymer paint composite was prepared in coating form. SEM images indicated a crack-free homogeneous fabrication of coating. The effect of poling was examined for piezocatalytic effect under ultrasonication. The performance of poled BaTiO3-polymer composite was superior to that of unpoled BaTiO3 composites. Samples showed repeatable performance to clean dye from an aqueous solution. These coatings were also effective in killing E. coli bacterial cells under ultrasonic vibration. In total, 80–90% RD dye degradation was recorded using poled BT samples under ultrasonication.
Author Contributions
Data curation, S.B.A.; methodology, S.K. and I.K.; resources, S.K.; supervision, R.V.; writing—original draft, N.A., S.K. and P.A.; writing—review & editing, I.B. and M.S.A.-B. All authors have read and agreed to the published version of the manuscript.
Funding
The authors express their gratitude to Princess Nourah bint Abdulrahman University Researchers Supporting Project (Grant No. PNURSP2022R291), Princess Nourah bint Abdulrahman University, Riyadh, Saudi Arabia. The authors extend their appreciation to the Deanship of Scientific Research at King Khalid University, Saudi Arabia, for funding this work through the Large Research Groups Program under grant number L.R.G.P2/171/43.
Data Availability Statement
The data that support the findings of this study are available on request from the corresponding author.
Conflicts of Interest
The authors declare that they have no known competing financial interest or personal relationships that could have appeared to influence the work reported in this paper.
References
- Wang, M.; Wang, B.; Huang, F.; Lin, Z. Enabling PIEZOpotential in PIEZOelectric Semiconductors for Enhanced Catalytic Activities. Angew. Chem. Int. Ed. 2019, 58, 7526–7536. [Google Scholar] [CrossRef] [PubMed]
- Starr, M.; Wang, X. Fundamental Analysis of Piezocatalysis Process on the Surfaces of Strained Piezoelectric Materials. Sci. Rep. 2013, 3, srep02160. [Google Scholar] [CrossRef] [PubMed]
- Djellabi, R.; Ordonez, M.F.; Conte, F.; Falletta, E.; Bianchi, C.L.; Rossetti, I. A review of advances in multifunctional XTiO3 perovskite-type oxides as piezo-photocatalysts for environmental remediation and energy production. J. Hazard. Mater. 2021, 421, 126792. [Google Scholar] [CrossRef] [PubMed]
- Liang, Z.; Yan, C.-F.; Rtimi, S.; Bandara, J. Piezoelectric materials for catalytic/photocatalytic removal of pollutants: Recent advances and outlook. Appl. Catal. B Environ. 2019, 241, 256–269. [Google Scholar] [CrossRef]
- Li, S.; Zhao, Z.; Zhao, J.; Zhang, Z.; Li, X.; Zhang, J. Recent Advances of Ferro-, Piezo-, and Pyroelectric Nanomaterials for Catalytic Applications. ACS Appl. Nano Mater. 2020, 3, 1063–1079. [Google Scholar] [CrossRef]
- Lin, E.; Kang, Z.; Wu, J.; Huang, R.; Qin, N.; Bao, D. BaTiO3 nanocubes/cuboids with selectively deposited Ag nanoparticles: Efficient piezocatalytic degradation and mechanism. Appl. Catal. B: Environ. 2021, 285, 119823. [Google Scholar] [CrossRef]
- Guo, L.; Zhong, C.; Cao, J.; Hao, Y.; Lei, M.; Bi, K.; Sun, Q.; Wang, Z.L. Enhanced photocatalytic H2 evolution by plasmonic and piezotronic effects based on periodic Al/BaTiO3 heterostructures. Nano Energy 2019, 62, 513–520. [Google Scholar] [CrossRef]
- Zhu, P.; Chen, Y.; Shi, J. Piezocatalytic Tumor Therapy by Ultrasound-Triggered and BaTiO3-Mediated Piezoelectricity. Adv. Mater. 2020, 32, e2001976. [Google Scholar] [CrossRef]
- Chen, L.; Li, H.; Wu, Z.; Feng, L.; Yu, S.; Zhang, H.; Gao, J.; Mai, Y.-W.; Jia, Y. Enhancement of pyroelectric catalysis of ferroelectric BaTiO3 crystal: The action mechanism of electric poling. Ceram. Int. 2020, 46, 16763–16769. [Google Scholar] [CrossRef]
- Hong, D.; Zang, W.; Guo, X.; Fu, Y.; He, H.; Sun, J.; Xing, L.; Liu, B.; Xue, X. High Piezo-photocatalytic Efficiency of CuS/ZnO Nanowires Using Both Solar and Mechanical Energy for Degrading Organic Dye. ACS Appl. Mater. Interfaces 2016, 8, 21302–21314. [Google Scholar] [CrossRef]
- Singh, G.; Sharma, M.; Vaish, R. Flexible Ag@LiNbO3/PVDF Composite Film for Piezocatalytic Dye/Pharmaceutical Degradation and Bacterial Disinfection. ACS Appl. Mater. Interfaces 2021, 13, 22914–22925. [Google Scholar] [CrossRef] [PubMed]
- Singh, G.; Sharma, M.; Vaish, R. Exploring the piezocatalytic dye degradation capability of lithium niobate. Adv. Powder Technol. 2020, 31, 1771–1775. [Google Scholar] [CrossRef]
- Zhang, D.; Su, C.; Li, H.; Pu, X.; Geng, Y. Synthesis and enhanced piezophotocatalytic activity of Ag2O/K0.5Na0.5NbO3 composites. J. Phys. Chem. Solids 2020, 139, 109326. [Google Scholar] [CrossRef]
- You, H.; Jia, Y.; Wu, Z.; Xu, X.; Qian, W.; Xia, Y.; Ismail, M. Strong piezo-electrochemical effect of multiferroic BiFeO3 square micro-sheets for mechanocatalysis. Electrochem. Commun. 2017, 79, 55–58. [Google Scholar] [CrossRef]
- Wu, J.; Qin, N.; Lin, E.; Yuan, B.; Kang, Z.; Bao, D. Synthesis of Bi4Ti3O12 decussated nanoplates with enhanced piezocatalytic activity. Nanoscale 2019, 11, 21128–21136. [Google Scholar] [CrossRef]
- Bößl, F.; Comyn, T.P.; Cowin, P.I.; García-García, F.R.; Tudela, I. Piezocatalytic degradation of pollutants in water: Importance of catalyst size, poling and excitation mode. Chem. Eng. J. Adv. 2021, 7, 100133. [Google Scholar] [CrossRef]
- Wang, J.; Hu, C.; Shi, L.; Tian, N.; Huang, H.; Ou, H.; Zhang, Y. Energy and environmental catalysis driven by stress and temperature-variation. J. Mater. Chem. A 2021, 9, 12400–12432. [Google Scholar] [CrossRef]
- Bößl, F.; Tudela, I. Piezocatalysis: Can catalysts really dance? Curr. Opin. Green Sustain. Chem. 2021, 32, 100537. [Google Scholar] [CrossRef]
- Sharma, M.; Vaish, R. Vibration energy harvesting for degradation of dye and bacterial cells using cement-based Ba0.85Ca0.15Zr0.1Ti0.90O3 composites. Mater. Today Commun. 2020, 25, 101592. [Google Scholar] [CrossRef]
- Sharma, M.; Singhal, T.; Vaish, R. Effect of ferroelectric polarization on piezo/photocatalysis in Ag nanoparticles loaded 0.5(Ba0.7Ca0.3)TiO3–0.5Ba(Zr0.1Ti0.9)O3 composites towards the degradation of organic pollutants. J. Am. Ceram. Soc. 2022, 105, 3165–3176. [Google Scholar] [CrossRef]
- Sharma, M.; Singh, G.; Vaish, R. Ag-nanoparticles-loaded Ba0.85Ca0.15Ti0.9Zr0.1O3 for multicatalytic dye degradation. Nanotechnology 2021, 32, 145716. [Google Scholar] [CrossRef] [PubMed]
- Abdurahman, M.H.; Abdullah, A.Z.; Shoparwe, N.F. A comprehensive review on sonocatalytic, photocatalytic, and sonophotocatalytic processes for the degradation of antibiotics in water: Synergistic mechanism and degradation pathway. Chem. Eng. J. 2020, 413, 127412. [Google Scholar] [CrossRef]
- Joseph, C.G.; Puma, G.L.; Bono, A.; Krishnaiah, D. Sonophotocatalysis in advanced oxidation process: A short review. Ultrason. Sonochem. 2009, 16, 583–589. [Google Scholar] [CrossRef] [PubMed]
- Chakma, S.; Moholkar, V.S. Investigation in mechanistic issues of sonocatalysis and sonophotocatalysis using pure and doped photocatalysts. Ultrason. Sonochem. 2015, 22, 287–299. [Google Scholar] [CrossRef] [PubMed]
- Ahmedchekkat, F.; Medjram, M.S.; Chiha, M.; Al-Bsoul, A.M.A. Sonophotocatalytic degradation of Rhodamine B using a novel reactor geometry: Effect of operating conditions. Chem. Eng. J. 2011, 178, 244–251. [Google Scholar] [CrossRef]
- Wang, Y.; Wen, X.; Jia, Y.; Huang, M.; Wang, F.; Zhang, X.; Bai, Y.; Yuan, G.; Wang, Y. Piezo-catalysis for nondestructive tooth whitening. Nat. Commun. 2020, 11, 1–11. [Google Scholar] [CrossRef]
- Sharma, M.; Singh, G.; Vaish, R. Piezocatalysis in ferroelectric Ba0.85Ca0.15Zr0.1Ti0.9O3/polyvinylidene difluoride (PVDF) composite film. J. Appl. Phys. 2021, 130, 085107. [Google Scholar] [CrossRef]
- Verma, S.; Sharma, M.; Vaish, R. Photo-piezocatalysis in electrospun PVDF + WS2 membrane. Environ. Sci. Nano 2022, 1–39. [Google Scholar] [CrossRef]
- Mondal, D.; Roy, S.; Bardhan, S.; Roy, J.; Kanungo, I.; Basu, R.; Das, S. Recent advances in piezocatalytic polymer nanocomposites for wastewater remediation. Dalton Trans. 2022, 51, 451–462. [Google Scholar] [CrossRef]
- Ma, W.; Yao, B.; Zhang, W.; He, Y.; Yu, Y.; Niu, J. Fabrication of PVDF-based piezocatalytic active membrane with enhanced oxytetracycline degradation efficiency through embedding few-layer E-MoS2 nanosheets. Chem. Eng. J. 2021, 415, 129000. [Google Scholar] [CrossRef]
- Sharma, M.; Vaish, R.; Ibrahim, S.M. Effect of poling condition on piezocatalysis activity of BaTiO3-cement composites. Mater. Lett. 2020, 280, 128583. [Google Scholar] [CrossRef]
- Singh, K.P.; Singh, G.; Vaish, R. Utilizing the localized surface piezoelectricity of centrosymmetric Sr1-xFexTiO3 (x ≤ 0.2) ceramics for piezocatalytic dye degradation. J. Eur. Ceram. Soc. 2021, 41, 326–334. [Google Scholar] [CrossRef]
- Su, R.; Wang, Z.; Zhu, L.; Pan, Y.; Zhang, D.; Wen, H.; Luo, Z.; Li, L.; Li, F.; Wu, M.; et al. Strain-Engineered Nano-Ferroelectrics for High-Efficiency Piezocatalytic Overall Water Splitting. Angew. Chem. Int. Ed. 2021, 60, 16019–16026. [Google Scholar] [CrossRef] [PubMed]
- Kumar, S.; Sharma, M.; Frömling, T.; Vaish, R. Antibacterial ferroelectric materials: Advancements and future directions. J. Ind. Eng. Chem. 2021, 97, 95–110. [Google Scholar] [CrossRef]
- Tan, G.; Wang, S.; Zhu, Y.; Zhou, L.; Yu, P.; Wang, X.; He, T.; Chen, J.; Mao, C.; Ning, C. Surface-Selective Preferential Production of Reactive Oxygen Species on Piezoelectric Ceramics for Bacterial Killing. ACS Appl. Mater. Interfaces 2016, 8, 24306–24309. [Google Scholar] [CrossRef]
- Sharma, M.; Singh, V.P.; Kumar, S.; Vaish, R. Multicatalytic behavior of Ba0.85Ca0.15Ti0.9Zr0.1O3 ceramics for pharmaceutical/dye/bacterial treatments. J. Appl. Phys. 2020, 127, 135103. [Google Scholar] [CrossRef]
- Ezraty, B.; Gennaris, A.; Barras, F.; Collet, J.-F. Oxidative stress, protein damage and repair in bacteria. Nat. Rev. Microbiol. 2017, 15, 385–396. [Google Scholar] [CrossRef]
- Kumar, A.; Pandey, A.K.; Singh, S.S.; Shanker, R.; Dhawan, A. Engineered ZnO and TiO2 nanoparticles induce oxidative stress and DNA damage leading to reduced viability of Escherichia coli. Free Radic. Biol. Med. 2011, 51, 1872–1881. [Google Scholar] [CrossRef]
- Sun, H.; Li, G.; Nie, X.; Shi, H.; Wong, P.K.; Zhao, H.; An, T. Systematic Approach to In-Depth Understanding of Photoelectrocatalytic Bacterial Inactivation Mechanisms by Tracking the Decomposed Building Blocks. Environ. Sci. Technol. 2014, 48, 9412–9419. [Google Scholar] [CrossRef]
- Wu, X.; Narsimhan, G. Synergistic effect of low power ultrasonication on antimicrobial activity of melittin against Listeria monocytogenes. LWT 2017, 75, 578–581. [Google Scholar] [CrossRef]
- Kumar, S.; Sharma, M.; Kumar, A.; Powar, S.; Vaish, R. Rapid bacterial disinfection using low frequency piezocatalysis effect. J. Ind. Eng. Chem. 2019, 77, 355–364. [Google Scholar] [CrossRef]
- Kumar, S.; Sharma, M.; Powar, S.; Kabachkov, E.; Vaish, R. Impact of remnant surface polarization on photocatalytic and antibacterial performance of BaTiO3. J. Eur. Ceram. Soc. 2019, 39, 2915–2922. [Google Scholar] [CrossRef]
Publisher’s Note: MDPI stays neutral with regard to jurisdictional claims in published maps and institutional affiliations. |
© 2022 by the authors. Licensee MDPI, Basel, Switzerland. This article is an open access article distributed under the terms and conditions of the Creative Commons Attribution (CC BY) license (https://creativecommons.org/licenses/by/4.0/).